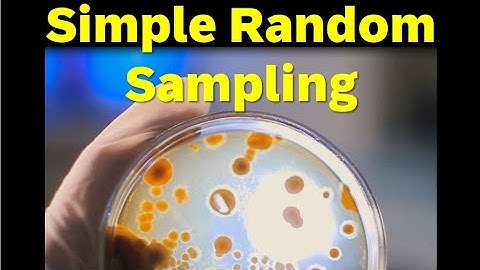
Advantage and Disadvantage of Simple Random Sampling

⬇ DOWNLOAD NOW
Kalau muncul iklan pop-up, tutup lalu klik tombol kembali
Download lagu Advantages & Disadvantages of Sampling Methods secara gratis hanya untuk keperluan promosi. Dukung artis favorit kamu dengan membeli musik original di iTunes atau platform resmi lainnya.
 Types of Sampling Methods (4.1)
Types of Sampling Methods (4.1)
 What Are The Types Of Sampling Techniques In Statistics - Random, Stratified, Cluster, Systematic
What Are The Types Of Sampling Techniques In Statistics - Random, Stratified, Cluster, Systematic
 Advantages and Disadvantages of Sampling
Advantages and Disadvantages of Sampling
 Sampling Methods 101: Probability & Non-Probability Sampling Explained Simply
Sampling Methods 101: Probability & Non-Probability Sampling Explained Simply
 What Are The Advantages And Disadvantages Of Non Probability Sampling? - The Friendly Statistician
What Are The Advantages And Disadvantages Of Non Probability Sampling? - The Friendly Statistician
 Sampling: Sampling & its Types | Simple Random, Convenience, Systematic, Cluster, Stratified
Sampling: Sampling & its Types | Simple Random, Convenience, Systematic, Cluster, Stratified
 What Are The Advantages And Disadvantages Of Probability Sampling? - The Friendly Statistician
What Are The Advantages And Disadvantages Of Probability Sampling? - The Friendly Statistician
Advantage and Disadvantage of Simple Random Sampling
Advantage and Disadvantage of Simple Random Sampling